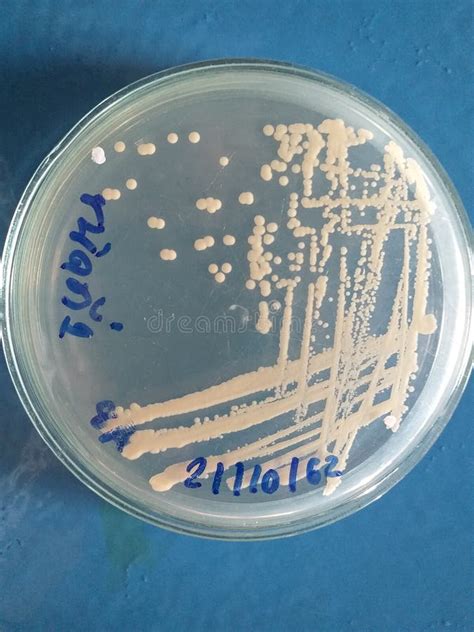

Il lievito di birra è un ingrediente fondamentale in molteplici settori, dalla panificazione alla birrificazione. Ottenere il lievito di birra all'ingrosso può rappresentare un vantaggio economico significativo per le attività che ne fanno un uso intensivo.
Tipologie di Lievito di Birra
Esistono diverse tipologie di lievito di birra, ognuna con caratteristiche specifiche che la rendono più adatta a determinati utilizzi:
- Lievito fresco: È il lievito più comune, venduto in blocchi e con una breve durata.
- Lievito secco attivo: Richiede una reidratazione prima dell'uso, ma ha una durata maggiore rispetto al lievito fresco.
- Lievito istantaneo: Può essere aggiunto direttamente agli ingredienti secchi, senza necessità di reidratazione.
Fattori che Influenzano i Prezzi all'Ingrosso
Diversi fattori possono influenzare i prezzi del lievito di birra all'ingrosso:
- Quantità acquistata: Generalmente, maggiore è la quantità acquistata, minore è il prezzo unitario.
- Tipologia di lievito: Il lievito fresco tende ad essere meno costoso del lievito secco attivo o istantaneo.
- Marca e produttore: Marche rinomate o produttori specializzati possono offrire lievito a prezzi più elevati.
- Canale di distribuzione: L'acquisto direttamente dal produttore o da un grossista può ridurre i costi rispetto all'acquisto da un rivenditore.
- Condizioni di mercato: Variazioni nella domanda e nell'offerta, nonché fattori economici generali, possono influenzare i prezzi.
Come Ottimizzare i Costi nell'Acquisto di Lievito di Birra all'Ingrosso
Per ottimizzare i costi nell'acquisto di lievito di birra all'ingrosso, è consigliabile:
- Confrontare diverse offerte: Richiedere preventivi a diversi fornitori per confrontare i prezzi e le condizioni di vendita.
- Pianificare gli acquisti: Acquistare quantità maggiori per ottenere sconti, tenendo conto della durata del lievito.
- Valutare alternative: Considerare l'utilizzo di lievito secco attivo o istantaneo, che hanno una durata maggiore e possono essere conservati più facilmente.
- Negoziare con i fornitori: Cercare di ottenere sconti o condizioni di pagamento favorevoli.

Conservazione del Lievito di Birra
La corretta conservazione del lievito di birra è essenziale per mantenerne la qualità e l'efficacia. Il lievito fresco deve essere conservato in frigorifero e utilizzato entro pochi giorni. Il lievito secco attivo e istantaneo devono essere conservati in un luogo fresco e asciutto, in un contenitore ermetico.
Tabella Comparativa dei Prezzi Medi (Esempio)
La seguente tabella fornisce un esempio dei prezzi medi all'ingrosso per diverse tipologie di lievito di birra. I prezzi possono variare a seconda del fornitore e delle quantità acquistate.
| Tipologia di Lievito | Unità di Misura | Prezzo Medio all'Ingrosso |
|---|---|---|
| Lievito Fresco | Kg | €2 - €4 |
| Lievito Secco Attivo | Kg | €8 - €12 |
| Lievito Secco Istantaneo | Kg | €10 - €15 |
Nota: I prezzi indicati sono puramente indicativi e possono variare.